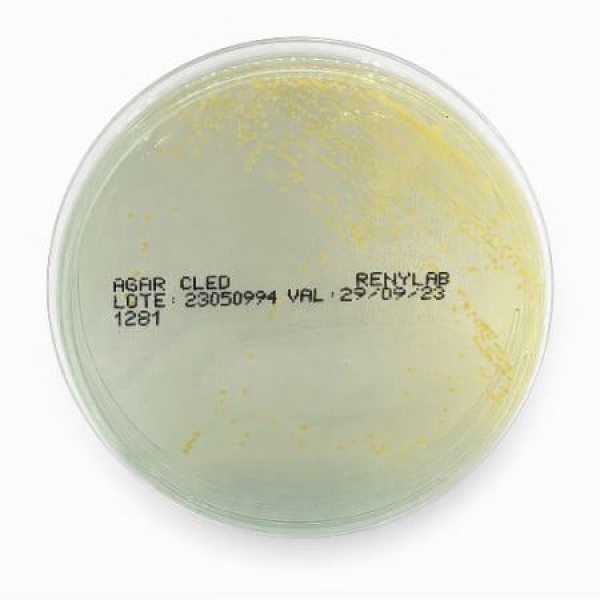
PLACA ÁGAR CLED, 90X15mm, PCT COM 10 UNID - RENYLAB

Nossos Produtos
Conheça nosso portfólio! Oferecemos uma ampla variedade de insumos e equipamentos para laboratórios, garantindo qualidade e inovação para o seu negócio.
PLACA ÁGAR CLED, 90X15mm, PCT COM 10 UNID - RENYLAB
Meio de cultura usado para isolamento e quantificação de microrganismos presentes em amostras de urina. A deficiência de eletrólitos inibe o véu de cepas de Proteus.